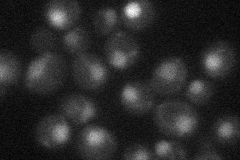
YJL194W
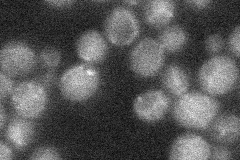
YJL194W
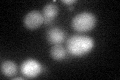
YJL194W
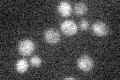
YJL194W

View description
Essential ATP-binding protein required for DNA replication, component of the pre-replicative complex (pre-RC) which requires ORC to associate with chromatin and is in turn required for Mcm2-7p DNA association; homologous to S. pombe Cdc18p
Localization:
Intensity:
Fold change:
Significance:
-
C’ GFP library in SD

nucleus18.11 -
N' NOP1pr-GFP in SD
nucleus16.6599 -
N' TEF2pr-mCherry in SD

below threshold4.2353 -
N' NATIVEpr-GFP in SD
below threshold19.8883 -
N' TEF2pr-VC and Cyto-VN in SD

#N/A0 -
C’ GFP library in SD+DTT
nucleus19.791.09No -
C’ GFP library in SD+H2O2

nucleus17.830.98No -
C’ GFP library in Starvation Media
nucleus17.880.98No -
C’ GFP library on the background of Pup2-DaMP

nucleus -
C’ GFP library on the background of CCT mutant

nucleus18.72521.03374No
